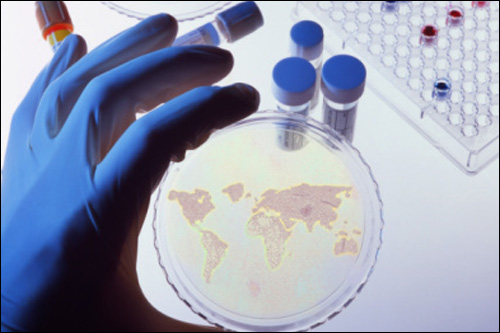

化工新材料
进展1:卤化丁基橡胶实现工业化生产。
2011年,燕山石化卤化年产3万吨丁基橡胶投产,结束了我国该胶种全部依赖进口的局面。2012年,浙江信汇合成新材料5万吨卤化丁基胶开始生产。
进展2:世界首套反式异戊橡胶工业化装置建成。
采用我国自主技术建设的世界首套万吨级合成反式异戊橡胶工业化生产装置在山东青岛莱西市李权庄工业园兴建,目前全部装置已经建成。我国是第一个拥有该工业技术的国家,且合成工艺原理也是世界首创。
进展3:动态硫化橡胶(TPV)实现工业化生产。
包括汽车高速列车密封用TPV新产品,建筑防水用TPV新产品,汽车传送带用TPV新产品。
进展4:热致相分离PVDF中空纤维膜。
TIPS法高性能PVDF中空纤维膜先进制造技术自2013年进入大规模生产与应用阶段,至今已实现销售额过亿元,产品已广泛应用于深度污水处理、工业废水回用、城市污水回用、海水淡化预处理等80多个项目,日处理水量达到百万吨。
进展5:国产渗透汽化膜在多个领域得到应用。
南京工业大学采用具有良好化学和热稳定性的多孔陶瓷膜作为支撑体,在其表面复合一层超薄、致密、无缺陷的有机分离层,从而开发了一系列具有自主知识产权的有机/无机复合渗透汽化膜。针对不同的应用体系和过程,复合膜的有机分离层包括疏水性的PDMS膜、亲水性的PVA膜以及通过物理掺杂的混合基质膜和化学改性的共混膜。该有机/无机复合膜被应用于多种典型的渗透汽化过程。目前已在异丙醇和酒精脱水中得到应用。
进展6:聚酰胺1212实现工业化生产。
聚酰胺(PA)俗称尼龙,超过10个碳链的尼龙称为长碳链尼龙,同普通PA树脂相比,长链PA具有吸水率低、尺寸稳定性好、韧性和柔软性好、耐磨损性能优异、电性能优异等特点,是目前国内外重点研究发展的领域。迄今为止,目前主要有法国ATO公司生产的PA11和由德国Huls公司、瑞士Emser公司投产的PA12,其他长链PA均没有实现规模化生产。国内自主开发的PA1212性能可完全替代进口PA12和PA11,目前已建成工业化装置。
进展7:新型内给电子体聚丙烯。
世界聚丙烯的生产能力达4000万吨以上,是世界合成树脂中产量最大的品种之一。聚丙烯催化剂绝大部分为第四代Ziegler-Natta聚丙烯催化剂,该体系的主催化剂的内给电子体为邻苯二甲酸酯,现已发现邻苯二甲酸酯对人体有很大的危害,我国于2003年开发了一类具有新型结构的化合物1,3-二醇酯,经过几年的研究,发现以该类化合物为内给电子体的催化剂具有活性高(比现有催化剂高40%以上)、共聚性能好等特点。目前已经工业化生产,累计生产新型聚丙烯树脂300万吨。中石化成为继巴塞尔公司之后第二个掌握该技术的企业。
进展8:对位芳纶和T700碳纤维工程化技术取得突破。
烟台氨纶、神马集团、常州兆达均宣布生产出合格的对位芳纶工业化产品。
中简科技、中复神鹰、西安康本、蓝星集团都宣布T700产业化装置建成。
芳纶重要原料苯二甲酰氯清洁生产工艺也已实现突破。
进展9:聚丙烯建筑模板已实现应用。
我国每年生产木质建筑模板约5000万平方米,若用PP替代,可大量节约木材;钢模板产量约6000万平方米,若用PP取代,可大大减轻重量,降低能耗。
进展10:无甲醛释放脲醛树脂实现工业化生产及应用。
以长链多醛预聚物作为脲醛胶的结构改性单元,将这种预聚物引入到脲醛树脂的反应中,使得脲醛树脂结构中形成长链烷基醚等稳定结构;同时结合后交联技术的使用,进一步提高人造板的胶结强度,并对树脂中剩下的微量羟甲基进行封端,消除由羟甲基引起的甲醛释放。这种新型脲醛树脂从高分子链结构上消除了易于分解释放甲醛的羟甲基、亚甲基醚等不稳定结构,因此其制造的人造板在使用过程中甲醛的释放达到≤0.3mg/L,接近零释放。
责任编辑:班英飞
《中国腐蚀与防护网电子期刊》征订启事
投稿联系:编辑部
电话:010-62313558-801
邮箱:ecorr_org@163.com
中国腐蚀与防护网官方 QQ群:140808414
官方微信
《中国腐蚀与防护网电子期刊》征订启事
- 投稿联系:编辑部
- 电话:010-62313558-806
- 邮箱:fsfhzy666@163.com
- 中国腐蚀与防护网官方QQ群:140808414


